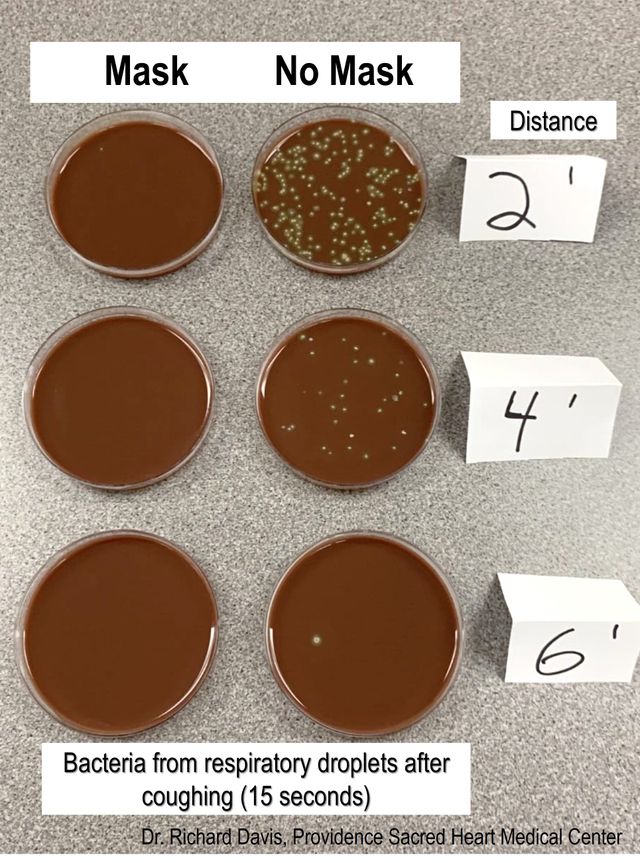
Вчений провів експеримент з медичною маскою і без неї: різниця колосальна - фото 413675
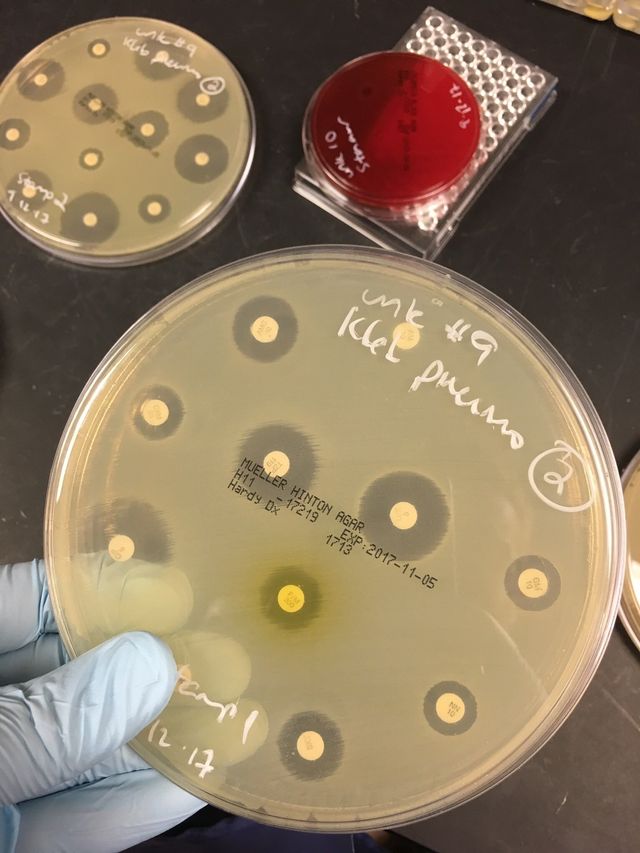
Вчений провів експеримент з медичною маскою і без неї: різниця колосальна - фото 413676

На вказану електронну адресу було надіслано повідомлення для підтвердження реєстрації
Вчений провів експеримент з медичною маскою і без неї: різниця колосальна
- 638
Навколо носіння масок під час пандемії коронавірусу чимало дезінформації. Науковці сперечаються щодо рівня їх захисту від коронавірусу, а люди впадають у крайнощі або носячи їх і на свіжому повітрі, або взагалі відкидаючи їх необхідність.
У відповідь на сумніви людей вчені та медики намагаються зупинити поширення дезінформації у соцмережах, публікуючи спростування популярних фейків про коронавірус та про роль масок зокрема.
До теми: У NASA представили прикрасу проти коронавірусу
Спеціально для тих, кому "маска не допомагає", учений Річ Девіс провів кілька демонстрацій з чашками Петрі, показавши, яке велике значення мають маски для зупинки розповсюдження крапель слини.
Важливо: вчений проводив експеримент з бактеріями, а не вірусами, тому цілком імовірно, що дрібніші краплі слини, які містять коронавірус, можуть затримуватись на довше та розповсюджуватись на більші відстані.
Для наочного прикладу доктор Девіс чхав, співав, розмовляв і кашляв на чашку Петрі. Результати з маскою і без неї разюче відрізняються:

Під час іншої демонстрації Девіс поставив чашки Петрі на відстані 60, 120 та 180 см і сильно кашляв упродовж близько 15 секунд у масці, а потім без неї. Як видно із кількості колоній бактерій, краплі здебільшого приземляються на відстані менше ніж 180 см, але маска блокує їх всіх з будь-якої дистанції.
Річ Девіс наголосив, що він в курсі, що бактерії діють не так, як віруси, але віруси, подібні до Sars-cov-2, поширюються саме через частинки слини.
Після публікації вченого завалили різноманітними питаннями, наприклад, як він змушував себе чхати по команді. Річ відповів, що для цього він нюхав чорний перець. Тож не нехтуйте правилами безпеки та зберігайте здоровий глузд. Носити маски під час прогулянок на свіжому повітрі не варто, але от в магазинах і транспорті – цілком виправдано.
Читайте також: Як зміниться система "шведський стіл" після пандемії коронавірусу
Цей матеріал має винятково інформаційний характер і не містить жодних порад, діагнозів чи висновків, що стосуються вашого здоров'я. Якщо вам потрібні встановлення діагнозу, консультація медика або лікування, зверніться до фахівця.
-
22:20Чому липень пролітає непомітно: психологи пояснили, чому цей місяць здається найкоротшим
-
22:19Всесвітній день кардіолога 2026: красиві привітання зі святом
-
21:40Що обов'язково потрібно зробити з кімнатними рослинами у липні: поради для здорового росту
-
21:22Яке свято відзначають 6 липня: традиції, заборони і прикмети на цей день
-
20:255 помилок під час прання, які непомітно псують ваш одяг: перевірте, чи не робите їх і ви
-
 Українські патріотичні пісні: плейлист, який підіймає дух
Українські патріотичні пісні: плейлист, який підіймає дух
-
19:41Незвичні голубці з сиром: простий рецепт ніжної страви, яка здивує смаком
-
18:35Картопляний салат із беконом і хріном – проста літня страва, яку захочеться готувати знову
-
17:35Балкон більше не комора: 7 простих ідей, які перетворять його на улюблене місце
-
07:15День Військово-морських сил ЗСУ 2026: красиві привітання зі святом
-
05:305 липня – неділя без масок: хто сьогодні почує те, що давно треба було сказати
- 04 липня
-
22:257 простих звичок, які допоможуть отримувати більше задоволення від життя щодня
-
21:22Яке свято відзначають 5 липня: традиції, заборони і прикмети на цей день
-
21:20Фейкові квартири та неіснуючі тури – як не стати жертвою шахраїв під час відпустки
-
 З Днем народження: топ 75 привітань у картинках, віршах, прозі та смс українською
З Днем народження: топ 75 привітань у картинках, віршах, прозі та смс українською
-
20:45Які ефірні олії допоможуть відлякати комах улітку: експерт назвав найефективніші
-
19:35Рис, картопля чи макарони – який гарнір найменше підвищує рівень цукру в крові
-
18:00Які помилки найчастіше роблять туристи в аеропорту – і як їх уникнути
-
17:35Куди поїхати в Польщі: 5 парків, які вражають своєю красою
-
15:00Чому полуниця виростає кислою: головні помилки у догляді
-
14:00Вишневий десерт без випікання: як приготувати ніжний смаколик із сирним кремом
-
13:00Кавун і диня можуть нашкодити: з якими продуктами їх не можна поєднувати влітку
-
12:00Речі, які краще заховати перед першим візитом чоловіка: вони зіпсують перше враження
-
11:00Конфлікт у колективі: 5 кроків мудрого керівника, які допоможуть зберегти сильну команду
-
10:35Як повернути скасовану пенсію: що треба зробити
-
21:22Яке свято відзначають 6 липня: традиції, заборони і прикмети на цей день
-
05:305 липня – неділя без масок: хто сьогодні почує те, що давно треба було сказати
- 04 липня
-
21:22Яке свято відзначають 5 липня: традиції, заборони і прикмети на цей день
-
13:00Кавун і диня можуть нашкодити: з якими продуктами їх не можна поєднувати влітку
-
09:00Тональний крем більше не потрібен: чим замінити його у спеку, щоб макіяж тримався довго
-
05:30Зірки радять 4 липня не повторювати старі помилки – і ось кому це особливо важливо
- 03 липня
-
21:22Яке свято відзначають 4 липня: традиції, заборони і прикмети на цей день
-
16:42Маша Кондратенко і Володимир Дантес представили трек "донт тач" про токсичне кохання
-
13:00Коли найкраще йти до лісу за грибами: названо ідеальний час для тихого полювання
-
05:30Гороскоп на 3 липня: п'ятниця, яка розставить усе по місцях – якщо не боятися чесності
- 02 липня
-
21:23Яке свято відзначають 3 липня: традиції, заборони і прикмети на цей день
-
05:302 липня – четвер деталей: хто зверне увагу на дрібниці, той уникне значних проблем
- 01 липня
-
21:22Яке свято відзначають 2 липня: традиції, заборони і прикмети на цей день
-
13:00“Невидимий” манікюр став головним трендом літа: 3 дизайни, які зроблять нігті доглянутими
-
09:00Собака буде здоровою і доглянутою: як часто потрібно купати улюбленця залежно від породи
-
05:30Новий місяць, нова енергія: 1 липня зірки радять зробити те, що давно лякало
- 30 червня
-
21:23Яке свято відзначають 1 липня: традиції, заборони і прикмети на цей день
-
19:00У липні буде кілька хвиль магнітних бур: чи будуть сильні та до чого варто готуватись
-
17:30Для затишних і теплих вечорів: добірка книжок, які варто прочитати цього літа
-
17:05Сини Брітні Спірс дебютували на подіумі під час Паризького тижня моди
-
17:00Робота на городі у самому розпалі: коли варто виходити на город у липні, а коли – ні
-
13:00Що взяти на пікнік: список речей, без яких відпочинок на природі може зіпсуватися
-
09:00Одна помилка – і троянди швидко зів’януть: як правильно доглядати за букетом у вазі
-
05:30Зірки назвали 4 знаки, яким 30 червня варто довіритися інтуїції більше, ніж логіці
- 29 червня
-
21:22Яке свято відзначають 30 червня: традиції, заборони і прикмети на цей день







